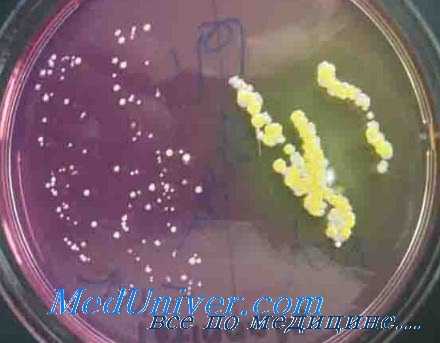
назокомиальные инфекции
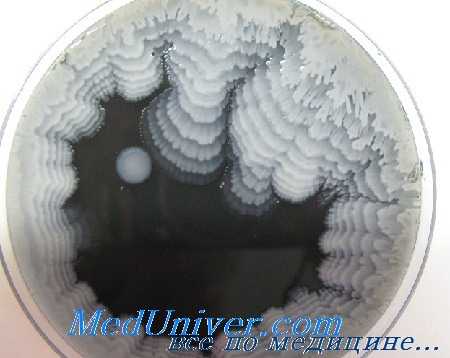
назокомиальные инфекции
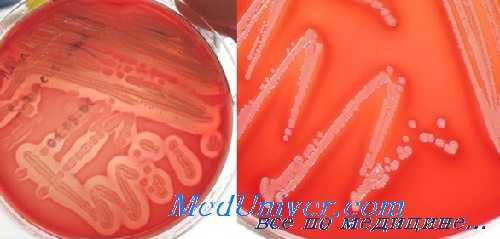
золотистый стафилококк S. aureus MRSA

Возбудители нозокомиальных инфекций (НКИ). Причины послеоперационной раневой инфекции
Добавил пользователь Skiper Обновлено: 23.01.2026
Возбудители послеоперационных инфекций. Этиология нозокомиальных инфекций (НКИ)
S. aureus — основной возбудитель поверхностных и глубоких абсцессов и послеоперационных РИ как в виде моноинфекции, так и в сочетании с другими возбудителями. Циркуляция MRSA делает золотистый стафилококк наиболее значимым возбудителем НКИ.
В последние годы 17-22% всех нозокомиальных инфекций (НКИ) в отечественных клиниках были обусловлены S. aureus. Носителями данного возбудителя оказались 11,3% персонала клиники, причем наиболее часто S. aureus колонизировал слизистую оболочку преддверия носа.
При проведении локального микробиологического мониторинга в отечественных больницах в 2003-2005 гг. у пациентов с поверхностными раневыми инфекциями в 44% случаев были выделены штаммы S. aureus, в том числе у 10% больных с инфекцией мочевых путей и у 36% больных с инфекцией дыхательных путей. Представляет интерес частота выделения S. aureus в различных микробных ассоциациях, при этом установлено, что моновариант S. aureus встречался только в 37,8% случаев.
В отечественных клиниках S. aureus был причиной более половины всех осложнений после операций на молочной железе, 11,2% урологических операций и 12,5% операций в области кожи и подкожной клетчатки.
Наряду с этим отмечается увеличение количества полирезистентных штаммов стафилококков и энтеробактерий. Доля MRSA в 2006 г. составила 62%, а продуцентов БЛРС среди штаммов кишечной палочки и клебсиелл-29%.
Частота инфекций, вызванных антибиотикорезистентными бактериями возрастает во всем мире с каждым днем. Такие инфекции повышают заболеваемость и смертность, а следовательно, и расходы на здравоохранение. Существует множество причин, объясняющих эту тенденцию, но главным фактором повышения числа антибиотикоустойчивых бактерий служит возрастание применения антимикробных препаратов, в особенности антибиотиков широкого спектра действия. Многие исследования показали, что приблизительно в 50% случаев применение антибиотиков нерационально.
Несмотря на то, что многочисленные многоцентровые исследования, проведенные в Европе, США, Канаде, показали, что ведущими возбудителями ИОХВ и РИ остаются штаммы золотистого стафилококка (частота выделения превышает 40%), кишечной палочки (> 10%), синегнойной палочки (> 12%) и энтерококков (> 4-6%), все больше специалистов сообщают о госпитальных грибковых инфекциях.
В отделениях сердечно-сосудистой хирургии США диагностируют более 10 грибковых осложнений на каждую тысячу госпитализированных больных, причем в этиологии нозокомиальных микозов на долю грибов рода Candida приходится 80-90%, Aspergillu sspp. — 1,3-2,5%; в единичных случаях обнаруживали редкие грибы Malassezia, Trichasporon, Mucor, Rhizopus, Fusarium, Acremonium, Alternaria и др.
Все чаще и чаще в биоматериалах пациентов в стационарах обнаруживают не Candida albicans, а более вирулентные и антибиотикорезистентные виды Candida non-albicans. По обобщенным данным США, Канады, Европы, Индии, Тайваня (всего 26 стран мира) сделан вывод о возрастающей роли грибов Candida поп-albicans в развитии кандидемии и других заболеваний. Среди 14 368 штаммов грибов рода Candida, выделенных от больных с системными микозами в 40 больничных лабораториях, получены следующие виды: С. albicans — 69%, С. glabrata — 10%, С. tropicalis — 4,2%, С. parapsilosis — 3,6%, С. krusei— 1,7%.

В Санкт-Петербурге у 50% больных с кандидемией в крови обнаружены С. albicans, у остальных - С. parapsilosis, С. tropicalis, С. glabrata, С. rugosa и др..
Кроме дрожжевых грибов Candida велика проблема заражения грибами рода Aspergillus в больницах, особенно в период проведения ремонтных и строительных работ.
Еще в 1993 г. французскими учеными описано 96 пациентов с аспергиллезом. Все эти больные относились к группам риска: трансплантация костного мозга и внутренних органов, СПИД, другие виды иммунодефицита. Среди всех больных после трансплантационных операций в 5-10% случаев возникал легочный аспергиллез, а смертность среди них составляла 62-82%.
Известно, что плесневыми грибами A. fumigatus, A. flavus, Penicillium spp. и другими могут быть загрязнены кондиционеры, воздух, вода, стены, пол, окна, цветы, занавески, мягкие игрушки и другие предметы в помещениях, стационаров что служит опасным фактором развития НКИ. При вдыхании контаминированного воздуха споры грибов попадают в легкие, а из них могут проникать в мозг, печень, селезенку, почки, щитовидную железу, сердце, кровеносные сосуды, кости, суставы, синусы, гениталии, кожу и другие органы. В результате может развиться инвазивный аспергиллез, летальность при котором составляет 60-70%.
В одной из волгоградских больниц брали пробы воздуха различных помещений и смывы с предметов с целью определить связь между нозокомиальной средой и микрофлорой пациентов. Более чем в 25 % всех смывов с объектов внешней среды обнаружены грибы Penicillium, Mucor, Aspergillus и др. — типичные обитатели почвы. В 28,6% проб воздуха высеяны мицелиальные грибы. При этом взаимосвязь между микрофлорой, выделенной от больных и из окружающей среды, в этом конкретном случае не выявлена.
В другом исследовании вспышек аспергиллеза в стационарах Санкт-Петербурга обнаружили концентрацию грибов A. fumigatus и A. flavus в воздухе больниц до нескольких сотен спор в 1 м3 воздуха. В кардиологических стационарах после операций по протезированию клапанов констатировали циркуляцию зигомицет в воздухе.
В Екатеринбурге проводили микологический мониторинг воздуха нозокомиальных помещений в соответствии с требованиями СанПиН 2.1.3. 1375-03 и благодаря противогрибковой дезинфекции снизили концентрацию грибов в воздухе с 150-240 до 70 КОЕ/м3.
Таким образом, достаточно актуальной остается проблема распространения грибов в окружающей среде и контаминация ими медицинских работников.

Во всем мире признано, что гигиена рук персонала в здравоохранении - основное условие борьбы с НКИ, т. к. при оказании медицинской помощи через руки могут быть переданы условно-патогенные микроорганизмы, в т. ч. и грибы.
Исследованиями в рамках NNIS показано, что с помощью ДНК-типирования подтверждена возможность передачи грибов Candida от пациента к пациенту и от медработника к пациенту.
Около 40% здоровых лиц из обслуживающего персонала в хирургических отделениях имеют колонизацию кожи рук грибами Candida. Через загрязненные руки может быть передана кандидозная инфекция, способствующая развитию системных микозов вплоть до кандидемии. При обследовании сотрудников различных ОРИТ в 1-54% случаев и более на коже рук обслуживающего персонала выделялись штаммы грибов Candida, идентичные таковым у пациентов.
Следует отметить, что в настоящее время имеются серьезные разработки по дезинфекции рук персонала, однако важно добиться обязательного выполнения этих правил.
Существуют также нормативные документы по санитарно-эпидемиологическому состоянию лечебных учреждений, но, к сожалению, обязательными признаны только методы определения грибов при контроле воздуха. Это еще раз подтверждает, что грибы Candida и Aspergillus не рассматриваются как равноправные возбудители НКИ.
Обращает на себя внимание полиэтиологичность нозокомиальных инфекций (НКИ). Обнаружение возбудителей НКИ создает дополнительные трудности диагностики, эпидемиологического исследования и лечения больных НКИ.
Следует отметить, что количественные параметры контаминации биологического материала микроорганизмами не всегда принимаются во внимание в связи с трудностью соблюдения оптимальных условий взятия материала и усложнением проведения анализа и идентификации выделенных культур микроорганизмов. Вместе с тем количественная характеристика принципиально важна, т. к. дает представление об интенсивности эпидемического процесса.
Чрезвычайно важным представляется изучение характеристик выделенных штаммов возбудителя. Необходимы поиски продуцентов БЛРС, MRSA, KHC, VRE как вариантов возбудителей НКИ с маркерами лекарственной устойчивости. Количество содержащих эти маркеры штаммов микроорганизмов в различных подразделениях колеблется: для MRSA — от 68 до 84%, для КНС - от 61 до 77 %, для VRE - от 0 до 37 %, для БЛРС - от 20 до 30%.
Изучение эпидемиологической ситуации и мониторинг локальной структуры антибиотикорезистентности возбудителей НКИ необходимо проводить в условиях конкретного стационара. Эти данные нельзя экстраполировать на другие лечебные учреждения и отделения, поэтому мониторинг антибиотикорезистентности возбудителей при разных формах НКИ — важный аспект деятельности лаборатории клинической микробиологии в каждой конкретной клинике.
При этом желателен компьютерный мониторинг возбудителей нозокомиальных инфекций (НКИ) с использованием адекватных методов статистической обработки результатов лабораторных исследований.
Редактор: Искандер Милевски. Дата обновления публикации: 18.3.2021
Возбудители нозокомиальных инфекций (НКИ). Причины послеоперационной раневой инфекции
Послеоперационные раневые инфекции (РИ) могут быть обусловлены широким спектром микроорганизмов, включая аэробные, факультативно-анаэробные и строго анаэробные бактерии, а также микобактерии и грибы. Для клинициста и клинического микробиолога важно получить информацию о точной идентификации микроорганизма, поскольку определенный вид микроба часто связан и с конкретным инфекционным осложнением, с типом послеоперационной раны. Микроскопия присланного в лабораторию биоматериала есть первое и обязательное условие грамотно организованной работы лаборатории.
Благодаря микроскопии можно не только решить, целесообразно ли делать посев присланного материала, по и во многих случаях дать предварительный результат (палочки, кокки, грибы, смешанная микрофлора или отсутствие микроорганизмов), а также рационально выполнить дальнейшие этапы микробиологического исследования. Результаты микроскопии следует всегда связывать с данными культуралыюго метода (посев на искусственные питательные среды, получение чистой культуры микроорганизма и точной идентификации).
Диагноз анаэробной инфекции, как правило, на первом этапе ставят по клиническим проявлениям. Что касается определения токсина С. difficile, результат может быть неспецифичеп, но тест весьма подходит как скрининг. При инфекции, обусловленной С. tetani (столбняк), микроскопия и посев часто дают отрицательные результаты (> 50%). При актиномикозе и нокардиозе очень важна предварительная микроскопия, поскольку в этих случаях (обнаружение морфологически сходных микроорганизмов) необходимо использовать специальные среды и длительную инкубацию, причем в случае актиномикоза инкубация посевов требует анаэробной атмосферы.
Структура лидирующих возбудителей в том или ином стационаре зависит от его профиля, принятых методов диагностики и лечения основного заболевания, применяемых схем антимикробной профилактики и терапии послеоперационных осложнений, а также от качества инфекционного контроля в клинике. Согласно кооперированным зарубежным данным, спектр возбудителей в клиниках Северной Америки, Европы, Азии, Австралии и даже Африки в основном сходный.
Наши данные по составу возбудителей также не отличаются от данных крупных международных исследований. Но частота их выделения, состав лидирующих возбудителей зависят от различных факторов, в т. ч. от профиля конкретного лечебного учреждения. Все связанные с НКИ проблемы наиболее ярко представлены в отделениях реанимации. При сравнении собственных результатов н данных Системы государственного надзора за нозокомнальными инфекциями США (NNIS) за 2003 г. очевидны значительные различия в частоте выделения всех основных возбудителей послеоперационных РИ, кроме E. coli и Enterococcus spp..
Частота выделения основных возбудителей нозокомиальных инфекций (НКИ) различна. Так, S.aureus, лидирующий в клиниках США, в РОНЦ выделяется более чем в 4 раза реже, остальные возбудители, напротив, чаще. Различия обусловлены многими факторами, в т. ч. и различным уровнем инфекционного контроля, отличной политикой антибиотикопрофилактики и антибиотикотерапии.
S. aureus занимает 1-е место в структуре возбудителей послеоперационных инфекционных осложнений в 50% рассматриваемых Н.В. Дмитриевой отделений РОНЦ, особенно в отделениях опухолей молочной железы (32,6%) и нейрохирургии (25,9%).
Е. coli лидирует как возбудитель в сравнении с S. aureus только в пяти отделениях: проктологии (22,7%), гинекологии (21,4%), рентген-хирургических методов диагностики и лечения (15,5%), отделениях радиохирургии (14,1%) и абдоминальной хирургии (11,9%). Значительную роль как возбудитель инфекций Е. coli играет в таких отделениях, как отделение опухолей женской репродуктивной системы (13,8%), урология (12,5%), диагностическое (10,8%), опухолей печени и поджелудочной железы (10,7%), опухолей верхних дыхательных и пищеварительных путей (8,7%).
Доля P. aeruginosa в отделениях реанимации в целом составила 18,5% (426 или 2297), что достоверно выше частоты инфекций, обусловленных Candida spp. (12,0%, 276 из 2297), A. baumannii (10,8%, 249 из 2297), К. pneumoniae (9,2%, 212 из 2297) и E.faecium (9,1 %, 210 из 2297), значение которых в данных отделениях также высоко. Следует отметить, что в ОРИТ № 1 (основное отделение реанимации для пациентов после хирургических операций) P. aeruginosa имеет первостепенное значение и составляет 19,6% (384 из 1958 штаммов), на 2-м месте A. baumannii (12,4%, 243 из 1958), затем идет Candida spp. (11,4%, 223 из 1958). В то же время в ОРИТ № 4 (отделение кардиореанимации) на 1-м месте стоит Candida spp. (15,6%, 53 из 339 штаммов), а уже затем P. aeruginosa (12,4%, 42 из 339). В обоих отделениях реанимации значение стафилококков как возбудителей инфекционных осложнений невелико.
Помимо отделений реанимации P. aeruginosa имеет либо основное, либо весьма существенное значение для всех остальных отделений. Так, в отделениях торакоабдоминальной хирургии и опухолей верхних дыхательных и пищеварительных путей это лидирующий возбудитель (14,5 и 16,3% соответственно). Отделения проктологии, урологии, нейрохирургии, радиохирургии, рентген-хирургических методов диагностики и лечения, опухолей головы и шеи, опухолей молочной железы также имеют значительную долю инфекций, обусловленных синегнойной палочкой.
A. baumannii занимает 1-е место (12,4%) в структуре возбудителей НКИ в отделении опухолей печени и поджелудочной железы, но статистически значимых различий по сравнению с Е. coli не наблюдается (10,7%). Частота выделения P. aeruginosa, К. pneumoniae, Е. faecalis и E.faecium ниже и примерно одинакова (около 8% для каждого возбудителя). Кроме отделения опухолей печени и поджелудочной железы A. baumannii составляет также значительную долю (12,5%) возбудителей в отделении опухолей головы и шеи после P. aeruginosa (13,2%) и лидирующего в этом отделении S. aureus (18,8%), хотя статистически значимой разницы в частоте их выявления в данном отделении не наблюдается.
Candida spp. — лидирующий возбудитель в ОРИТ № 4 (15,6%), а в четырех других отделениях стоит на 2-м месте по частоте выделения: ОРИТ № 1 (11,4%), торакоабдоми-нальной хирургии (11,2%), абдоминальной хирургии (10,7%) и опухолей верхних дыхательных и пищеварительных путей (8,7%).
E. faecalis занимает 1-е место в структуре возбудителей послеоперационных инспекционных осложнений только одного отделения — урологического (15%), на 2-м месте в этом отделении Е. coli (12,5%) и P. aeruginosa (11,8%), хотя статистически значимых различий в частоте их выделения не отмечается.
Группа коагулазонегативных стафилококков (КГС) в основном представлена двумя клинически значимыми видами: S. epidermidis и S. haemolyticus. В отделении реконструктивной и сосудистой хирургии S. epidermidis (19,5%) наравне с S. aureus (19,1 %) — наиболее значимые возбудители, статистически значимо реже встречается E.faecalis (11,4%). В трех отделениях S. epidermidis занимает 2-е место после 5. aureus: отделение опухолей молочной железы (23,9%), отделение опухолей женской репродуктивной системы (18,2%) и отделение общей онкологии (14,1 %).
К. pneumoniae составляет в целом по клинике 7,4%. Только в одном отделении (нейрохирургия) этот вид энтеробактерий имеет существенное значением занимает 2-е место, составляя 16,7%.
S. maltophilia, несмотря на то что нечасто выделяется из биоматериалов пациентов хирургических отделений и составляет только 3,7%, имеет большое значение как возбудитель НКИ. С каждым годом доля этого вида грамотрицательных неферментирующих палочек в общей структуре возбудителей растет во всех странах. Кроме того, при инфекции, обусловленной S. maltophilia, весьма ограничен выбор антимикробных препаратов (триметоприм/сульфаметоксазол [Бисептол] и тикарпиллип/клавулаповая кислота [Тиментин]).
Таким образом, несмотря на то что в целом по клинике лидирующим возбудителем следует считать P. aeruginosa, отделения отличаются но спектру возбудителей и микроорганизмам, имеющих основное значение. Принципиально важно понимать, что эмпирическая антимикробная терапия должна быть конкретизирована и адаптирована к условиям определенного стационара. Следует отметить, что применение антибиотика с уровнем резистентности 10-20% является достоверно высоким, поэтому рекомендуется избегать их назначения.
Эпидемиология послеоперационной раневой инфекции. Распространенность
В последние десятилетия наблюдается значительный прогресс в области терапевтических и хирургических технологий, фармакологии и трансплантации органов, что приводит к значительному снижению показателей заболеваемости и смертности. Но, несмотря на эти достижения, больные онкологических стационаров, лечебных учреждений общего профиля, хирургических и терапевтических отделений интенсивной терапии, входят в группу риска оппортунистических инфекций.
Вплоть до конца ХIХ в. основная часть населения Европы и Северной Америки умирала от инфекций, вызываемых «классическими» патогенными бактериями (возбудители холеры, чумы, брюшного тифа, туберкулеза, сибирской язвы и др.). Эти микроорганизмы принято называть облигатно-патогенными. В последние десятилетия отмечается рост медицинского значения группы микроорганизмов, называемых факультативно-патогенными, или оппортунистическими возбудителями инфекций.
В сравнении с «классическими» патогенными микроорганизмами оппортунистические возбудители относятся к нормальной микрофлоре человека или присутствуют в окружающей среде. При определенных условиях некоторые микроорганизмы этой группы могут вызывать тяжелые инфекции, которые регистрируются как в амбулаторной практике, так и в условиях стационара. Факультативно-патогенные микроорганизмы часто вызывают инфекции у лиц с иммунодефицитом.
В развитых странах, по данным международных исследований, около 5-20% больных приобретают инфекцию именно в процессе госпитализации; в развивающихся странах эта цифра достигает 25-40%. Заболеваемость, летальность и затраты, связанные с нозокомиальной инфекцией (НКИ), особенно в последние десятилетия, растут в большинстве стран. В России ежегодно регистрируется примерно 60000 случаев НКИ, но их предполагаемое число значительно больше и может составить 2,5 млн.
В США проводится более 30 млн операций в год, из них более 30% — это операции высокого риска. При этом стоимость пребывания одного больного с послеоперационной раневой инфекцией (РИ) составляет 1398 долларов США. По данным Американского общества по инфекционным заболеваниям, послеоперационные РИ в США — это только 3% всех НКИ, но затраты на их лечение составляют 25 % общей стоимости НКИ.
К симптомам послеоперационной раневой инфекции (РИ) могут относиться местная эритема, болезненность, припухлость, боль, расхождение краев раны и выделение гнойного экссудата. Поскольку местные признаки воспаления иногда трудно интерпретировать и они не всегда связаны с инфекцией, и инфицированной послеоперационной раной обычно считают рану, из которой выделяется гнойный экссудат. Опасность инфицирования послеоперационной раны зависит от вероятности ее контаминации микроорганизмами.

До введения в широкую практику профилактического применения антибиотиков частота инфекции при «чистых» операциях составляла 1-2% и менее, при «условно-чистых» — 6-9%, при «контаминированных» -13-20%, при «грязных» операциях — около 40%. Частота послеоперационных инфекций с введением профилактического применения антибиотиков снизилась до 3,3% при «условно-чистых» операциях, до 6,4% — при «контамипированных» и до 7,1% при «грязных».
Летальность при послеоперационной раневой инфекции (РИ колеблется от 0,25-2% в кардиохирургии до 30-35% при перитонитах в зависимости от анатомической области операционного поля, тяжести инфекции, основного заболевания, сопутствующих заболеваний. Летальность при послеоперационной РИ в случае своевременной и адекватной антимикробной терапии в 2 раза ниже по сравнению с несвоевременным и неадекватным лечением.
Без сомнения, грамотно организованный инфекционный контроль в такой ситуации имеет огромное значение. Качество инспекционного контроля в том или ином лечебном учреждении, особенно в стационаре, отражает качество оказания медицинской помощи. Для снижения частоты НКИ требуется информация о наиболее распространенных возбудителях инфекции, их чувствительности к антимикробным препаратам. Микробиологические исследования, проведенные па современном уровне, позволяют создать необходимую базу данных по нескольким направлениям:
• выявление всего спектра возбудителей инфекционных осложнений каждого конкретного стационара;
• определение таксономической структуры основных возбудителей нозокомиальной инфекции (НКИ) и уровня их резистентности (устойчивости) к антимикробным препаратам.
Создание подобной базы данных играет важную роль в инфекционном контроле нозокомиальной инфекции (НКИ), их профилактике и лечении, предотвращении вспышек нозокомиальной инфекции (НКИ), обусловленных полирезистентными штаммами микроорганизмов (MRSA метициллин-резистентный S.aureus, MRS-KHC - метициллин-резистептные коагулазонегативные стафилококки, VRE — ванкомицин-резистентные энтерококки, БЛРС — продуценты b-лактамаз расширенного спектра действия и др.). Организация инфекционного контроля определяет приоритетное значение микробиологических исследований среди других видов лабораторной диагностики.
Высокий уровень микробиологических исследований подразумевает точную идентификацию микроорганизма, которая невозможна без использования в рутинной работе современных приборов, таких как гем-анализаторы для работы с образцами крови, приборы по точной идентификации микроорганизмов до вида, микробиологические анализаторы но определению чувствительности возбудителей инфекции к антимикробным препаратам. В основе анализаторов для определения чувствительности к антибиотикам лежит выявление минимальной подавляющей концентрации (МПК) препарата.
На современном этапе в практической работе клиническим микробиологам следует уйти от диско-диффузионного метода определения чувствительности микроорганизмов к антимикробным препаратам, заменив его на выявление чувствительности на основе определения МПК. Внедрение приборов в рутинную работу микробиологов позволяет достичь стандартизации, максимально исключить влияние каких-либо случайностей, и особенно человеческого фактора, па конечный результат. Немаловажно, что стандартизация всей работы в ходе микробиологического исследования обеспечивает получение данных, которые будут сравнимы с результатами серьезных публикуемых отечественных и зарубежных исследований.
Золотистый стафилококк (S. aureus) как причина раневых инфекций. Резистентность к антибиотикам MRSA
Посев крови редко может помочь клиницистам в диагностике послеоперационных раневых инфекций в области брюшной полости. Интраабдоминальные инфекции это распространенная проблема, стоящая на 2-м месте среди наиболее частых причин летальности от инфекции. По зарубежным данным, рост из крови микроорганизма, идентичного микроорганизму из инфицированной послеоперационной раны, регистрируется в 0% случаев при аппендэктомии и достигает 5% при наличии чрескожных дренажных устройств. При инфицированных послеоперационных ранах наиболее целесообразно назначать посев крови больным отделения реанимации, где летальность от инфекции высока.
В хирургии 15,2% бактериемии обусловлены S. aureus и статистически значимо связаны с летальностью. Зависимость развития послеоперационной бактериемии от вида микроорганизма, выделенного из рапы, более значима, чем от типа хирургической операции. Выявление S. aureus в ране - независимый фактор риска послеоперационной стафилококковой бактериемии с летальностью до 16%.
Анализ чувствительности Staphylococcus spp. касается в первую очередь препаратов, имеющих основное клиническое значение.
В отношении метициллин-чувствительных стафилококков (MSSA, MSSE), следует упомянуть группу фторхинолонов, применяемых для лечения стафилококковых инфекций (особенно кожи и мягких тканей), например левофлоксацин (Таваник) и моксифлоксацин (Авелокс), которые обладают более высокой активностью при стафилококковых инфекциях в сравнении с традиционными препаратами данной группы. Между этими антибиотиками нет полной перекрестной резистентности. По нашим данным, для трех наиболее часто выделяемых видов стафилококков (S. aureus, S. epidermidis, S. haemolylicus) моксифлоксацин статистически значимо более эффективен in vitro по сравнению с левофлоксацином.

Как правило, препаратами выбора для лечения стафилококковых инфекций служат b-лактамные антибиотики. Существует два основных механизма устойчивости стафилококков к этой группе препаратов: продукция b-лактамаз или наличие дополнительного пенициллинсвязывающего белка (ПСБ2а). Выявление этих механизмов и четкое их разграничение у конкретных штаммов стафилококков позволяют точно прогнозировать эффективность всей группы b-лактамных антимикробных препаратов без необходимости определения чувствительности к каждому препарату в отдельности.
В связи с этим следует руководствоваться следующими правилами при анализе антибиотикограммы стафилококков:
• чувствительность к бензилпенициллину/ампициллииу: штамм не имеет механизмов резистентности. Можно прогнозировать чувствительность ко всем остальным b-лактамным антибиотикам (например, к цефазолипу, цефотаксиму и др.). Препараты выбора: природные пенициллины (например, бензилпенициллин — пенициллин G);
• устойчивость к бензилпенициллину/ампициллину, но чувствительность к оксациллину/метициллину: штамм продуцирует ферменты b-лактамазы (пенициллиназы), способные разрушать природные и полусинтетические пенициллины.
В данном случае можно применять b-лактампые антибиотики с потенциальной антистафилококковой активностью (антистафилококковые пенициллины, цефалоспорипы I, II, IV поколений, карбапеиемы). Препараты выбора: ингибиторзащищенные пенициллины (например, амоксициллин/клавуланат — Амоксиклав, Аугментин) или цефалоспорипы I (например, цефазолин - Кефзол) и II (например, цефуроксим) поколений;
• устойчивость и к бензилпенициллину/ампициллину, и к оксациллину/метициллину: штамм имеет ПСБ2а, следовательно, все b-лактамные антибиотики клинически будут неэффективны, даже если в антибиотикограмме будет указана чувствительность к ним.
Для штаммов с истинной оксациллин/метициллин-резистентностью характерна ассоциированная резистентность к антибиотикам и других групп (например, к гентамицину, клиндамицину, ципрофлоксацину и др.). Препараты выбора: гликопептиды (ванкомицин), вторая линия — оксазолидиноны (линезолид). Таким образом, определение чувствительности стафилококков к антибиотикам в рутинной работе при определенных обстоятельствах можно ограничить двумя тестами: определение чувствительности к бензилпенициллипу и оксациллипу (выявление истинной резистентности к оксациллипу подразумевает выявление гена тесА, кодирующего синтез ПСБ2а).
По нашим данным, при послеоперационных раневых инфекциях штаммы S. aureus, обладающие истинной резистентностью к оксациллину (MRSA), составляют всего 9,5% (39 из 410), что статистически значимо ниже в сравнении с коагулазонегативными стафилококками (КНС). Так, 66,9% (204 из 305) штаммов S. epidermidis и 100% (191 из 191) штаммов S. haemolyticus были расценены как метициллин-резистентные коагулазонегативные стафилококки (КНС).
MRSA важный нозокомиальный патоген, составляющий более 50% НКИ в США, один из основных возбудителей послеоперационных раневых инфекций (РИ). Доля MRSA в структуре послеоперационных раневых инфекций (РИ) в США выросла С 9% в 1995 г. до 30% в 2000 г. с атрибутивной летальностью 21 %.
J.J. Engemann и соавт. изучили влияние MRSA на исход при послеоперационных инфекциях у 479 больных и пришли к выводу, что летальность у больных без инфекции составила всего 2,1%, при инфекции, обусловленной метициллин-чувствительными S. aureus (MSSA), — 6,7%, что статистически значимо выше, чем в случае без инфекции. Для MRSA летальность была статистически значимо выше, чем в каждом из предыдущих случаев, — 20,7%. Кроме того, стоимость лечения возрастала с 29 455 долларов США в случае без инфекции до 52 791 долларов при MSSA и достигала 92 363 долларов при MRSA.
Таким образом, экономические потери и увеличение летальности при хирургических инфекциях, обусловленных MRSA и MR-КНС, очевидны.
Пациенты больниц и медицинские работники по сути представляют собой потенциальный резервуар для штаммов MRSA, любые меры по уменьшению значимости этих резервуаров могут способствовать снижению НКИ, обусловленных MRSA. Весьма эффективным может быть выявление носителей штаммов MRSA среди медработников, а также обследование больных перед госпитализацией путем исследования слизистой оболочки полости носа с последующей санацией выявленных носителей или их изоляцией. Выделение специальных помещений для больных, колонизированных или инфицированных штаммами MRSA, с ограничением их передвижения в пределах больницы уже не только признано целесообразным, по и имеет место на практике во многих зарубежных клиниках.
Для лечения взрослых больных с послеоперационными раневыми инфекциями, обусловленными MRSA, рекомендован ряд препаратов: ванкомицин, линезолид, даптомицин, тигециклин, телеванцин. В недалеком будущем будет доступен новый антибиотик цефтаролин (цефалоспорин, Зинфоро). Хотя новые антибиотики с эффективностью против MRSA по сравнению с вапкомицином не демонстрируют особых преимуществ. Следует обращать внимание на то, какие штаммы циркулируют в конкретном стационаре: если МПК ванкомицина в отношении S. aureus не более 2 мкг/мл, назначать ванкомицин можно при его клинической эффективности, по в случае МПК > 2 мкг/мл (VISA штамм со сниженной чувствительностью ванкомицину, VRSA — ванкомицин резистентный штамм) следует переходить на альтернативные препараты.
По данным отечественных стационаров чувствительность к ванкомицину всех исследованных в ходе мониторинга штаммов стафилококков высока, но статистически значимо ниже для S. epidermidis по сравнению с S. aureus и S. haemolyticus. Эффективность линезолида (Зивокс) и тигециклина in vitro составляет 100% в отношении всех видов стафилококков.
Раневая инфекция
Раневая инфекция – это комплекс общих и местных патологических проявлений, возникающих при развитии инфекции в случайных или операционных ранах. Патология проявляется болью, ознобом, лихорадкой, увеличением регионарных лимфатических узлов и лейкоцитозом. Края раны отечные, гиперемированные. Наблюдается выделение серозного или гнойного отделяемого, в отдельных случаях образуются участки некроза. Диагноз выставляется на основании анамнеза, клинических признаков и результатов анализов. Лечение комплексное: вскрытие, перевязки, антибиотикотерапия.
МКБ-10
Общие сведения
Раневая инфекция – осложнение раневого процесса, обусловленное развитием патогенной микрофлоры в полости раны. Все раны, в том числе и операционные, как в гнойной хирургии, так и в травматологии считаются первично загрязненными, поскольку какое-то количество микробов попадает на раневую поверхность из воздуха даже при безукоризненном соблюдении правил асептики и антисептики. Случайные раны загрязнены сильнее, поэтому в таких случаях источником инфекции обычно является первичное микробное загрязнение. При операционных ранах на первый план выступает эндогенное (из внутренней среды организма) или внутригоспитальное (вторичное) инфицирование.
Причины
В большинстве случаев возбудителем инфекции в случайных ранах становится стафилококк. Редко в качестве основного возбудителя выступает протей, кишечная и синегнойная палочка. В 0,1% случаев встречается анаэробная инфекция. Через несколько дней пребывания в стационаре флора меняется, в ране начинают преобладать устойчивые к антибактериальной терапии грамотрицательные бактерии, которые обычно становятся причиной развития раневой инфекции при вторичном инфицировании как случайных, так и операционных ран.
Раневая инфекция развивается в случае, когда количество микробов в ране превышает некий критический уровень. При свежих травматических повреждениях у ранее здорового человека этот уровень составляет 100 тыс. микроорганизмов на 1 г ткани. При ухудшении общего состояния организма и определенных особенностях раны этот порог может существенно снижаться.
К числу местных факторов, повышающих вероятность развития раневой инфекции, относится присутствие в ране инородных тел, сгустков крови и некротических тканей. Также имеет значение плохая иммобилизация при транспортировке (становится причиной дополнительной травмы мягких тканей, вызывает ухудшение микроциркуляции, увеличение гематом и расширение зоны некроза), недостаточное кровоснабжение поврежденных тканей, большая глубина раны при малом диаметре раневого канала, наличие слепых карманов и боковых ходов.
Общее состояние организма может провоцировать развитие раневой инфекции при грубых расстройствах микроциркуляции (централизация кровообращения при травматическом шоке, гиповолемические расстройства), нарушениях иммунитета вследствие недостаточного питания, нервного истощения, химических и радиационных поражений, а также хронических соматических заболеваний. Особенно значимы в таких случаях злокачественные новообразования, лейкемия, уремия, цирроз, сахарный диабет и ожирение. Кроме того, снижение сопротивляемости инфекции наблюдается при проведении лучевой терапии и при приеме ряда лекарственных средств, в том числе – иммунодепрессантов, стероидов и больших доз антибиотиков.
Классификация
В зависимости от преобладания тех или иных клинических проявлений гнойные хирурги выделяют две общие формы раневой инфекции (сепсис без метастазов и сепсис с метастазами) и несколько местных. Общие формы протекают тяжелее местных, вероятность летального исхода при них повышается. Самой тяжелой формой раневой инфекции является сепсис с метастазами, который обычно развивается при резком снижении сопротивляемости организма и раневом истощении вследствие потери больших количеств белка.
К числу местных форм относятся:
- Инфекция раны. Является локализованным процессом, развивается в поврежденных тканях с пониженной сопротивляемостью. Зона инфицирования ограничена стенками раневого канала, между ней и нормальными живыми тканями есть четкая демаркационная линия.
- Околораневой абсцесс. Обычно соединен с раневым каналом, окружен соединительнотканной капсулой, отделяющей участок инфекции от здоровых тканей.
- Раневая флегмона. Возникает в случаях, когда инфекция выходит за пределы раны. Демаркационная линия исчезает, процесс захватывает прилежащие здоровые ткани и проявляет выраженную тенденцию к распространению.
- Гнойный затек. Развивается при недостаточном оттоке гноя вследствие неадекватного дренирования или зашивании раны наглухо без использования дренажа. В подобных случаях гной не может выйти наружу и начинает пассивно распространяться в ткани, образуя полости в межмышечных, межфасциальных и околокостных пространствах, а также в пространствах вокруг сосудов и нервов.
- Свищ. Образуется на поздних стадиях раневого процесса, в случаях, когда на поверхности рана закрывается грануляциями, а в глубине сохраняется очаг инфекции.
- Тромбофлебит. Развивается через 1-2 мес. после повреждения. Является опасным осложнением, обусловлен инфицированием тромба с последующим распространением инфекции по стенке вены.
- Лимфангит и лимфаденит. Возникают вследствие других раневых осложнений, исчезают после адекватной санации основного гнойного очага.
Симптомы раневой инфекции
Как правило, патология развивается спустя 3-7 дней с момента ранения. К числу общих признаков относится повышение температуры тела, учащение пульса, ознобы и признаки общей интоксикации (слабость, разбитость, головная боль, тошнота). В числе местных признаков – пять классических симптомов, которые были описаны еще во времена Древнего Рима врачом Аулусом Корнелиусом Сельсусом: боль (dolor), местное повышение температуры (calor), местное покраснение (rubor), отек, припухлость (tumor) и нарушение функции (functio laesa).
Характерной особенностью болей является их распирающий, пульсирующий характер. Края раны отечны, гиперемированы, в полости раны иногда имеются фибринозно-гнойные сгустки. Пальпация пораженной области болезненна. В остальном симптоматика может варьироваться в зависимости от формы раневой инфекции. При околораневом абсцессе отделяемое из раны нередко незначительное, наблюдается выраженная гиперемия краев раны, резкое напряжение тканей и увеличение окружности конечности. Образование абсцесса сопровождается снижением аппетита и гектической лихорадкой.
При раневых флегмонах выявляется существенное повышение местной температуры и резкое ухудшение состояния больного, однако рана выглядит относительно благополучно. Формирование гнойного затека также сопровождается значительным ухудшением состояния пациента при относительном благополучии в области раны. Температура повышается до 40 градусов и более, отмечаются ознобы, вялость, адинамия и снижение аппетита. Гнойное отделяемое отсутствует или незначительное, гной выделяется только при надавливании на окружающие ткани, иногда – удаленные от основного очага инфекции. При свищах общее состояние остается удовлетворительным или близким к удовлетворительному, на коже формируется свищевой ход, по которому оттекает гнойное отделяемое.
Осложнения
Осложнения обусловлены распространением инфекции. При гнойных тромбофлебитах общее состояние ухудшается, в зоне поражения определяются умеренные признаки воспаления, при расплавлении стенки вены возможно формирование флегмоны или абсцесса. Лимфангит и лимфаденит проявляются болезненностью, отечностью мягких тканей и гиперемией кожи в проекции лимфатических узлов и по ходу лимфатических сосудов. Отмечается ухудшение общего состояния, ознобы, гипертермия и повышенное потоотделение. При сепсисе состояние тяжелое, кожа бледная, наблюдается снижение АД, выраженная тахикардия, бессонница и нарастающая анемия.
Лечение раневой инфекции
Лечение заключается в широком вскрытии и дренировании гнойных очагов, а также промывании раны антисептиками. В последующем при перевязках используются сорбенты и протеолитические ферменты. В фазе регенерации основное внимание уделяется стимуляции иммунитета и защите нежных грануляций от случайного повреждения. В фазе эпителизации и рубцевания при больших, длительно незаживающих ранах выполняют кожную пластику.
Прогноз и профилактика
Прогноз определяется тяжестью патологии. При небольших ранах исход благоприятный, наблюдается полное заживление. При обширных глубоких ранах, развитии осложнений требуется длительное лечение, в ряде случаев возникает угроза для жизни. Профилактика раневой инфекции включает в себя раннее наложение асептической повязки и строгое соблюдение правил асептики и антисептики в ходе операций и перевязок. Необходима тщательная санация раневой полости с иссечением нежизнеспособных тканей, адекватным промыванием и дренированием. Пациентам назначают антибиотики, проводят борьбу с шоком, алиментарными нарушениями и белково-электролитными сдвигами.
Читайте также:
- Затруднения интубации двухпросветной трубкой. Терапевтическое использование бронхоспирометрии
- Психоневрозы мужчин. Андрогенизм у мужчин
- Рентгенограмма, КТ, МРТ при надблоково-локтевой мышце
- Имплантация интраокулярной линзы (ИОЛ) при дислокации хрусталиковых масс. Принципы
- Принципы операции при травме аорты над почечными артериями. Тактика
